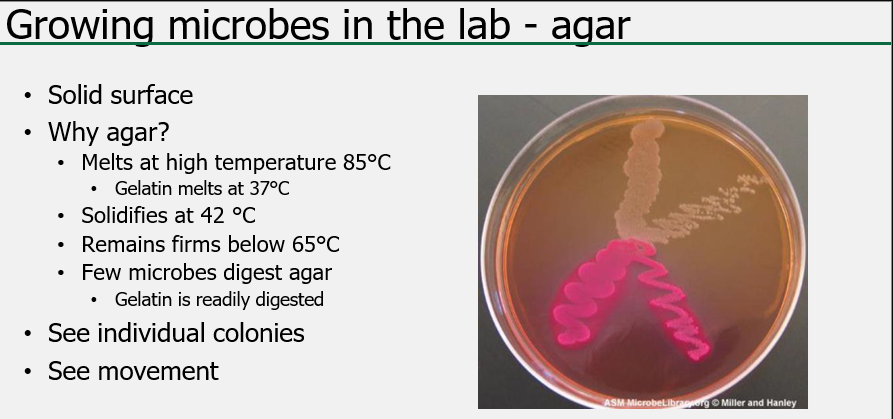

What is metabolism?
Chemical reactions in the cell
-Exergonic reactions are spontaneous and release energy
-Endergonic reactions require energy to procede
Anabolism:
-endergonic metabolic pathway involved in biosynthesis, converts simple molecule building blocks into more complex molecules fuelled by the use of cellular energy
Catabolism:
-Exergonic pathway that breaks down complex molecules into simpler ones
-Molecular energy stored in the bonds of complex molecules
What are the metabolic classes in microorganisms?
-Lithotrophy is unique to the bacterial and archaeal domains

How can microbes generate energy using respiration?
What is aerobic respiration?
-Respiration happens in the presence (oxic) of oxygen
-Terminal electron acceptor is oxygen
What is anaerobic respiration?
-Absence (anoxic) of oxygen
-Terminal electron acceptor is something other than oxygen (anaerobic)
-inorganic: denitrification, sulfate reduction, ferric iron, manganic ion, selenate, arsenate, uranyl
-Organic: fumarate, dimethyl sulfoxide, CO2 (methane)
What is fermentation?
Final electron acceptor: organics (usually pyruvate)
-Is not anaerobic respiration because it lacks a respiratory chain

Compare and contrast aerobic respiration, anaerobic respiration and fermentation
-ATP yield: Fermentation < anaerobic < aerobic

Associate homofermentation and heterofermentation with their end products
-Homo: lactic acid
-Hetero: lactic acid, ethanol, carbon dioxide, acetic acid
Describe how light is used to generate ATP and oxygen
Associate oxygenic and anoxygenic with their end products
Describe how bacteria fix carbon dioxide and nitrogen
-Process requires either an anaerobic environment or a mechanism by which the enzyme is protected from exposure to O2

Describe how bacteria divide and the bacterial cycle
Binary fission: 1 cell becomes 2 cells (doubles)
Chromosome replication:
- Chromosome is duplicated resulting in a bacterial cell with 2 chromosome
Elongation:
-The cell wall, membrane(s) and cytoplasm expand resulting in a longer/larger bacterial cell with 2 chromosomes
Segregation:
-Each copy of the chromosome are moved to a different pole resulting in longer/larger cell with a chromosome at each pole
Z-ring formation:
-The septum starts forming resulting in a longer/larger cell with cleavage furrow and a chromosome at each pole
Division;
-The septum closes resulting in 2 identical cells of “normal” size
Describe the steps of the bacterial growth curve

Describe the steps of biofilm formation
- reversible attachment
- irreversible attachment
- growth
- maturation
- detachment/dispersion
-Free living planktonic to attached community
-Not a target of antibiotics
Explain how we measure growth and count microbes. Compare and contrast methods
How can you calculate growth rate and generation time
Describe the different approaches used to cultivate microbes. Compare and contrast
Define auxotroph, prototroph, eutrophs/copiotrophs and oligotrophs
Oligotroph: requires low nutrient level to grow (high nutrient level prevents growth)
Prototroph: self sufficient-generate their own macromolecules form basic elements
Copiotroph: grow in high levels of nutrient
Auxotroph: requires the addition of macromolecules because it does not synthesize them
What are the different types of growth media and their purposes?

Why do we use agar instead of gelatin?
What are the temperature requirements for growing specific bacteria?

What are the oxygen requirements for the following:
Microaerophiles
Obligate aerobes
Aerotolerant anaerobes
Obligate anaerobes
facultative anaerobes

Microaerophiles: aerobic respiration only
Obligate aerobes: aerobic respiration only
Aerotolerant anaerobes: fermentation only
Obligate anaerobes: anaerobic respiration and/or fermentation
Facultative anaerobes: aerobic respiration and fermentation

What are the ranges of pH that certain bacteria grow in?

What are the ranges of salt concentration and their respective bacterial growth?



